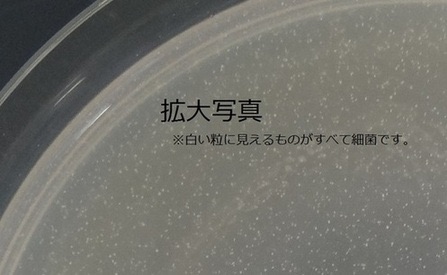

1 名前:風吹けば名無し 投稿日:2021/04/16 10:24:02 ID:whZLzl+Vp.net
【悲報】鶴瓶の麦茶、負ける
おすすめ記事
2 名前:風吹けば名無し 投稿日:2021/04/16 10:24:04 ID:QKaI40PFp.net
爽健美茶「500…?」
生茶「500」(ホッ
おーいお茶「500」
鶴瓶「550」
爽健美茶「????550!」
生茶「550」
おーいお茶「5…560!」
鶴瓶「580」
爽健美茶「……600!!」
セブンプレミアム「600!」
鶴瓶「630」
セブンプレミアム「…630!!」
鶴瓶「650」
鶴瓶「670」
鶴瓶「680」
やかんの麦茶「950」
10 名前:風吹けば名無し 投稿日:2021/04/16 10:26:00 ID:HVMRt6Id0.net
>>2
逝ったああああああああ
20 名前:風吹けば名無し 投稿日:2021/04/16 10:27:04 ID:6F/Vk/XTx.net
>>2
これは落札
57 名前:風吹けば名無し 投稿日:2021/04/16 10:32:03 ID:VkfkKzAr0.net
>>2
草
218 名前:風吹けば名無し 投稿日:2021/04/16 10:48:01 ID:WbGje8BC0.net
>>2
なんで同じメーカーで争ってるんや!
14 名前:風吹けば名無し 投稿日:2021/04/16 10:26:04 ID:tiL+CmzjM.net
問題は値段よ
17 名前:風吹けば名無し 投稿日:2021/04/16 10:27:03 ID:QKaI40PFp.net
もう持ち運ぶレベルじゃないのよ
18 名前:風吹けば名無し 投稿日:2021/04/16 10:27:03 ID:DUc82QGu0.net
デカイな
海外サイズや
21 名前:風吹けば名無し 投稿日:2021/04/16 10:27:05 ID:hZeHVkaQ0.net
同価格で勝負せえや
23 名前:風吹けば名無し 投稿日:2021/04/16 10:28:01 ID:jyWcsRx80.net
値段見つけた
「やかんの麦茶」は、“やかんで煮出した麦茶”のような本格的でしっかりとした味わい。20~40代をターゲットに展開する。
ラインナップは、650mlPET/140円、600mlPET(自販機向け)/140円、950mlPET/156円、2LPET/331円(いずれも税別)の4種類。
なお、現在発売中の「茶流彩彩 麦茶」は、新製品発売後に順次終売となる。
29 名前:風吹けば名無し 投稿日:2021/04/16 10:29:01 ID:Clhpt4ZHa.net
>>23
こんなの950買うやん
手首への負担すごそうやけど
35 名前:風吹けば名無し 投稿日:2021/04/16 10:30:01 ID:tUAvpj/bd.net
>>23
やっす
63 名前:風吹けば名無し 投稿日:2021/04/16 10:32:04 ID:ThJoRe9s0.net
>>23
650やんけ…
93 名前:風吹けば名無し 投稿日:2021/04/16 10:36:01 ID:vMEzCds8a.net
>>23
2リットル買うより950を2本買う方が15円も安いやんけ
101 名前:風吹けば名無し 投稿日:2021/04/16 10:36:05 ID:MVTCK5Wl0.net
>>23
やっすいなあ
105 名前:風吹けば名無し 投稿日:2021/04/16 10:37:00 ID:K9Z5+ckqa.net
>>23
鶴瓶は670で税抜き140円なんだが
まだ鶴瓶が勝ってる
113 名前:風吹けば名無し 投稿日:2021/04/16 10:37:04 ID:jyWcsRx80.net
>>105
あとはどこまで小売が安売りするかやからな
135 名前:風吹けば名無し 投稿日:2021/04/16 10:40:01 ID:Mmp6aZE2d.net
>>23
950買いたいけど持ち歩けんわ
161 名前:風吹けば名無し 投稿日:2021/04/16 10:42:04 ID:PfISCQQk0.net
>>23
”合格”や
200 名前:風吹けば名無し 投稿日:2021/04/16 10:46:02 ID:GBSYxmqH0.net
>>23
安いのは安いんやな
ようやく対抗馬出てきたか
37 名前:風吹けば名無し 投稿日:2021/04/16 10:30:02 ID:jy69G090p.net
ドロリッチを見習え
39 名前:風吹けば名無し 投稿日:2021/04/16 10:30:03 ID:tTPeBU9e0.net
これが健全な競争やね
46 名前:風吹けば名無し 投稿日:2021/04/16 10:31:03 ID:wQEWqv4zd.net
鶴瓶は夏にむけてまだ調整中やぞ
62 名前:風吹けば名無し 投稿日:2021/04/16 10:32:04 ID:lQ2CV+Kl0.net
72 名前:風吹けば名無し 投稿日:2021/04/16 10:33:04 ID:fI8V7bHJp.net
>>62
草
106 名前:風吹けば名無し 投稿日:2021/04/16 10:37:01 ID:QRSTazYWa.net
>>62
麦茶カラーかわいいな
225 名前:風吹けば名無し 投稿日:2021/04/16 10:48:03 ID:5BkBa6Qca.net
>>62
ええなこれ
64 名前:風吹けば名無し 投稿日:2021/04/16 10:33:00 ID:sSRjP9k/d.net
950mlは流石にでかくて持ち歩けない
67 名前:風吹けば名無し 投稿日:2021/04/16 10:33:02 ID:jyWcsRx80.net
79 名前:風吹けば名無し 投稿日:2021/04/16 10:34:04 ID:mj0F/kV+H.net
>>67
鶴瓶も2リットル売っとるやん
なんで600ちょっとがもてはやされとるんや?
89 名前:風吹けば名無し 投稿日:2021/04/16 10:35:03 ID:4F2MecU40.net
>>79
コンビニで買えるからやないの
96 名前:風吹けば名無し 投稿日:2021/04/16 10:36:02 ID:jyWcsRx80.net
>>79
でっかいの買うんやったらパックでええねん
81 名前:風吹けば名無し 投稿日:2021/04/16 10:34:05 ID:UtGVlNStM.net
>>67
これ鶴瓶の勝ちじゃん
83 名前:風吹けば名無し 投稿日:2021/04/16 10:35:00 ID:0dkAHc+Xp.net
>>67
1Lで鶴瓶の勝ちやん
69 名前:風吹けば名無し 投稿日:2021/04/16 10:33:04 ID:rAtkYNbCp.net
デカすぎんだろ
500と同じ大きさで950にしろよ
77 名前:風吹けば名無し 投稿日:2021/04/16 10:34:03 ID:HVMRt6Id0.net
麦茶のせいで他のお茶もどんどん増量する羽目になったの草
小さいままだと見劣りするもんな
78 名前:風吹けば名無し 投稿日:2021/04/16 10:34:04 ID:4CR6U4VU0.net
86 名前:風吹けば名無し 投稿日:2021/04/16 10:35:03 ID:HVMRt6Id0.net
>>78
やさしい麦茶が鶴瓶軍に取り込まれてて草
117 名前:風吹けば名無し 投稿日:2021/04/16 10:38:00 ID:nIxz/0YR0.net
>>78
濃縮タイプが一瞬鶴瓶タイプに見えたわ
121 名前:風吹けば名無し 投稿日:2021/04/16 10:38:03 ID:NeIUqeD/0.net
>>78
はい鶴瓶の勝ち
92 名前:風吹けば名無し 投稿日:2021/04/16 10:36:01 ID:mLaQnQ48M.net
115 名前:風吹けば名無し 投稿日:2021/04/16 10:38:00 ID:CSiPdeyt0.net
>>92
草
128 名前:風吹けば名無し 投稿日:2021/04/16 10:39:02 ID:7OZ6VZQo0.net
>>92
くさ
133 名前:風吹けば名無し 投稿日:2021/04/16 10:40:01 ID:jyWcsRx80.net
>>92
こういうのって球場でも起きとるよな
190 名前:風吹けば名無し 投稿日:2021/04/16 10:45:01 ID:3l+lBUgq0.net
>>92
つよい
119 名前:風吹けば名無し 投稿日:2021/04/16 10:38:02 ID:zdYIM3Icp.net
129 名前:風吹けば名無し 投稿日:2021/04/16 10:39:03 ID:jyWcsRx80.net
>>119
1日で飲み切る事考えたら500ml前後でええんよな
でかいの買うとコップに注ぐ前提になってまう
139 名前:風吹けば名無し 投稿日:2021/04/16 10:40:03 ID:JvmGFSSu0.net
>>119
やっぱ糖分最強やな
152 名前:風吹けば名無し 投稿日:2021/04/16 10:41:03 ID:TQ48RF5p0.net
>>119
無糖のコーヒーは?
158 名前:風吹けば名無し 投稿日:2021/04/16 10:42:02 ID:V0REKByf0.net
>>119
砂糖入っとるヤツこんな強かったんか
195 名前:風吹けば名無し 投稿日:2021/04/16 10:45:05 ID:5quXi0Bf0.net
>>158
砂糖や塩は細菌に強いねん
せやから昔から砂糖漬けや塩漬けは保存食になっとるやろ?
142 名前:風吹けば名無し 投稿日:2021/04/16 10:40:04 ID:Hz+bD9wh0.net
ティーバッグの麦茶コスパ良すぎてペットボトルのやつ買えんわ
154 名前:風吹けば名無し 投稿日:2021/04/16 10:41:05 ID:RrdzjSgX0.net
>>142
日常用はそれでええけど
スポーツするとき用やと冷凍できるペットボトルが最強
143 名前:風吹けば名無し 投稿日:2021/04/16 10:40:05 ID:P2FiWKo50.net
そろそろガロン投入くるか?
157 名前:風吹けば名無し 投稿日:2021/04/16 10:42:01 ID:8crwNSqZr.net
そういや鶴瓶の抱き枕あったよな
アレほしかったけど応募忘れてたわ
159 名前:風吹けば名無し 投稿日:2021/04/16 10:42:02 ID:4qLYpX/ua.net
鶴瓶麦茶あんま美味くないやろ
162 名前:風吹けば名無し 投稿日:2021/04/16 10:42:05 ID:RrdzjSgX0.net
>>159
お茶なんて、ほうじ茶とジャスミン茶以外全部同じだろ
171 名前:風吹けば名無し 投稿日:2021/04/16 10:43:04 ID:4qLYpX/ua.net
>>162
使ってる水が違うというか飲んだあとの口の中の感覚が違うわ
185 名前:風吹けば名無し 投稿日:2021/04/16 10:44:05 ID:VY44eqGfM.net
189 名前:風吹けば名無し 投稿日:2021/04/16 10:45:01 ID:Clhpt4ZHa.net
>>185
増量の申し子
215 名前:風吹けば名無し 投稿日:2021/04/16 10:47:05 ID:16RjVD9zr.net
>>185
もう鶴瓶首相やってくれ
201 名前:風吹けば名無し 投稿日:2021/04/16 10:46:02 ID:2qsQOH0.net
1リットルペットボトルちょうどいいのに100ローにしか置いてない
212 名前:風吹けば名無し 投稿日:2021/04/16 10:47:03 ID:jyWcsRx80.net
>>201
あれ場所取る割に売れないんやろ
204 名前:風吹けば名無し 投稿日:2021/04/16 10:47:00 ID:SYuUapgMp.net
問題は味だろ
コカコーラの作る麦茶ってうまいんか?
207 名前:風吹けば名無し 投稿日:2021/04/16 10:47:02 ID:S75Qr5Jc0.net
流石は世界のコカコーラさんやで
208 名前:風吹けば名無し 投稿日:2021/04/16 10:47:02 ID:9tlCREV00.net
麦茶はパックのやつでいいだろ
216 名前:風吹けば名無し 投稿日:2021/04/16 10:48:01 ID:IWE+AkJNa.net
>>208
パックだと1L5円くらいだよな
226 名前:風吹けば名無し 投稿日:2021/04/16 10:48:05 ID:q5v8zSmk0.net
値段は?
今出とる綾鷹と爽健美茶の950mLはコンビニ価格168円やけど
129円以下にせんと勝ちにはならへんぞ
229 名前:風吹けば名無し 投稿日:2021/04/16 10:49:03 ID:jyWcsRx80.net
>>226
税込みだとそれと一緒ぐらいかも
227 名前:風吹けば名無し 投稿日:2021/04/16 10:49:00 ID:H7Ww5mczp.net
コカコーラのお茶系って色々出たけど爽健美茶だけしか生き残らなかったな
243 名前:風吹けば名無し 投稿日:2021/04/16 10:50:05 ID:pUPigaAH0.net
でもワイは鶴瓶にするわ
245 名前:風吹けば名無し 投稿日:2021/04/16 10:51:01 ID:9CUef1C/p.net
キャンペーンやってる内は鶴瓶の勝ちや
塩と麦貰いまくるで
伊藤園 健康ミネラルむぎ茶 600ml×24本
http://www.amazon.co.jp/exec/obidos/ASIN/B01BV15M3G/gurum-22/ref=nosim/

引用元:http://tomcat.2ch.sc/test/read.cgi/livejupiter/1618536265/

マジレスすると味次第
ペットボトル麦茶の中では伊藤園のが一番好みだわ
ワイはペットボトルはインド飲みするから無問題や
鶴瓶を首相にして消費税増量されたらかなわんからやめてくれ
伊藤園も1リットルの奴細くしてくれれば持ち歩きやすいのに
夏場は外にいるとそれくらい飲むよなあ
コカコーラの作った綾鷹「…」
50ml減ったと捉えるべきでは。
ℓの鶴瓶見慣れてるから>>1見てもピンと来ない
増量キング鶴瓶が負けるはずはない!
みんな鶴瓶応援してて笑う
自分もだけど
500ml棚に置けないのはレギュレーション違反です
子供が、ちゅるびちょうだい(鶴瓶ちょうだい=麦茶ちょうだい)と言えるようになったから、コレからも健康ミネラル麦茶。
国産大麦じゃないので
ミネラル推しの方がいいな
ワイ、麦茶飲むと腹下す激弱胃腸の持ち主。
もう何十年も麦茶飲んでない。
鶴瓶の麦茶マジ不味い
飲むと気持ち悪くなるんだけど何が入ってるんだろ?